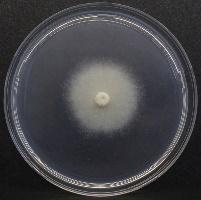
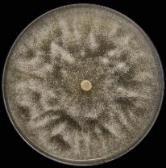
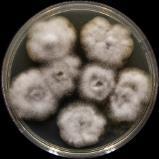

Arbusti ornamentali da fiore




























Specie arboree forestali/ornamentali
(Pinaceae)

Le piante acidofile, pur essendo molto apprezzate per la loro resistenza, rusticità e bellezza ornamentale, possono andare incontro a diverse avversità fitosanitarie, sia biotiche che abiotiche, soprattutto se non coltivate in condizioni ottimali, come in terreni inadatti, con pH troppo elevato o soggetti a una gestione irrigua scorretta.
Principali avversità abiotiche (problemi ambientali o colturali)
1. Substrati di crescita inadatti
2. Mancanza di microelementi
3. Stress idrico
4. Danni da gelo
5. Bruciature fogliari
Principali avversità biotiche (patogeni e parassiti)
1. Insetti a altri artropodi parassiti
2. Batteriosi
3. Virosi
4. Funghi e oomiceti patogeni












Le acidofile sono particolarmente sensibili al substrato di crescita e all’irrigazione)
Afidi Ragnetto rosso

Danni al fogliame
Ingiallimento delle foglie
Melata
Perdita di vigore dei getti

Tetranychus urticae


Decolorazione e danni
Accartocciamento del fogliame
Caduta delle foglie
Prospera in caso di deficit idrico


Ingiallimento e caduta delle foglie
Melata
Fumaggine
Stephanitis spp.


Macchie e danni alle foglie
Perdita di vigore
Deperimento
azalee, rododendri e pieris particolarmente suscettibili
Oziorinco

Danni al fogliame

Tripidi

Decolorazioni
Trasmissione di virosi (agenti vettori)
Lepidotteri fitofagi


Danni al fogliame
Indebolimento della pianta
Le infestazioni da insetti sono particolarmente frequenti sulle
acidofile ma anche facilmente
risolvibili con metodi preventivi o
attivi, biologici e chimici a seconda del parassita coinvolto
METODI PREVENTIVI DI CONTENIMENTO
• Monitoraggio periodico per individuare
nuove infestazioni in fase latente o iniziale
• Cura e pulizia delle piante
• Mantenere la pianta in salute
• Insetticidi preventivi (sistemici)

METODI ATTIVI DI CONTENIMENTO
• Cattura degli insetti (trappole)
• Rimozione manual degli individui
• Insetticidi attivi e olio di neem

• Lotta biologica (coccinelle o Bacillus)
Fattori biotici

Malattie infettive
Funghi
Oomiceti
Batteri
Fitoplasmi
Virus
Patologia vegetale
Fattori abiotici
Fisiopatie
Stress termici
Stress idrici
Carenze o eccessi di minerali
Carenza/eccesso di radiazione
Agenti atmosferici
Salinità
Inquinanti

Entomologia
Gli insetti non causano “malattie” ma danni




BATTERIOSI
Malattie batteriche che possono colpire le piante che richiedono un terreno acido (a basso pH)
Necrosi fogliari, avvizzimento dei germogli e fiori, cancri sui rami e sul tronco, e deformazioni dei tessuti.
I sintomi possono variare a seconda della pianta ospite e del batterio specifico.
Le condizioni di umidità e la presenza di ristagni idrici possono favorire lo sviluppo di queste malattie.
L'eccessivo calcare nel terreno può rendere le piante più suscettibili alle infezioni.
esempio: Pseudomonas syringae


Le virosi sono malattie causate da virus che possono compromettere la salute e la crescita. I sintomi possono variare, ma spesso includono ingiallimento e screziatura fogliare, deformazioni, nanismo e ridotta produzione.

La trasmissione avviene principalmente attraverso vettori, come insetti che si nutrono della linfa della pianta (es. afidi, cicaline, mosche, cimici, ecc.) oppure con contatto con piante o parti di piante infette.
La prevenzione è fondamentale, poiché non esistono cure dirette per le virosi, e si basa principalmente sul controllo dei vettori (insetti che trasmettono il virus) e sull'utilizzo di materiale vegetale sano.



Es. virus del mosaico della camelia
Sintomi aspecifici → la diagnosi è essenziale
A volte le virosi sono utilizzate per ottenere piante ornamentali con foglie screziate
I funghi rappresentano i principali patogeni delle piante, in grado di causare numerose malattie a carico di tutti gli organi; anche le piante acidofile sono suscettibili alle infezioni fungine, che spesso provocano sintomi gravi e possono portare alla morte della pianta.
Tra le più comuni troviamo la muffa grigia (botrite), le ruggini, l'oidio (o mal bianco) e i marciumi delle foglie, frutti e radicali. Queste malattie possono manifestarsi con macchie sulle foglie, marciume, appassimento e necrosi delle parti colpite.
• Funghi ascomiceti
• Funghi basidiomiceti
• Cromisti oomiceti

MARCIUME RADICALE DA PHYTOPHTHORA: la minaccia principale per le acidofile (in particolare le Ericaceae)



Sintomi primari
Marciume radicale e del colletto
Necrosi radicali
Essudati


Sintomi secondari aspecifici
Declino vegetativo, clorosi
Morte repentina

MARCIUME RADICALE DA PHYTOPHTHORA: la minaccia principale per le acidofile (in particolare le Ericaceae)
Organismi primitivi strettamente correlati all’acqua


Particolarmente

Ciclo biologico ed epidemiologico Micelio



Phytophthora spp.

Il vivaio rappresenta l’ambiente ottimale per la riproduzione e la diffusione di queste specie patogene:
• Utilizzo abbondante dell’acqua
• Uso e riuso di substrati infetti
• Presenza ravvicinata di specie vegetali diverse, anche esotiche (salto d’ospite facilitato)
• Rischio di introduzione in ambiente naturale, urbano e in agricoltura
270 specie conosciute → crescita esponenziale di nuove specie descritte PATOGENI EMERGENTI ALTAMENTE INVASIVI

In Italia oltre 50 specie segnalate
solo marciumi radicali…
Infezioni aeree da
parte di specie di Phytophthora più evolute

Sporangi caduchi

Phytophthora ramorum →parassita da quarantena EPPO A2


Necrosi fogliari
Avvizzimento dei getti
Marciume dei frutti
Cancri aerei



Rododendro particolarmente suscettibile
Created by Biorender

Caratterizzazione morfologica



Caratterizzazione molecolare ITS BETA TUBULIN cox1
Numerosi agrofarmaci efficaci contro le malattie tradizionali


Principi attivi
Azoxistrobina
Cimoxanil
Difenoconazolo
Fosetil alluminio
Isopyrazam
Mancozed Metalaxil
Ossicloruro di rame
Tebuconazolo
Trifloxistrobina
Ziram etc etc…

Fumaggine

Maculature e necrosi fogliari





Tecniche agronomiche corrette


Selezione di varietà più resistenti e rustiche
METODI PREVENTIVI


Lotta biologica con antagonisti (es. Trichoderma spp.)

Ridurre uso di agrofarmaci come
Aliette e Ridomil (sviluppo resistenza) e trattare con ammendanti speciali
METODI ATTIVI


carlo.bregant@unipd.it